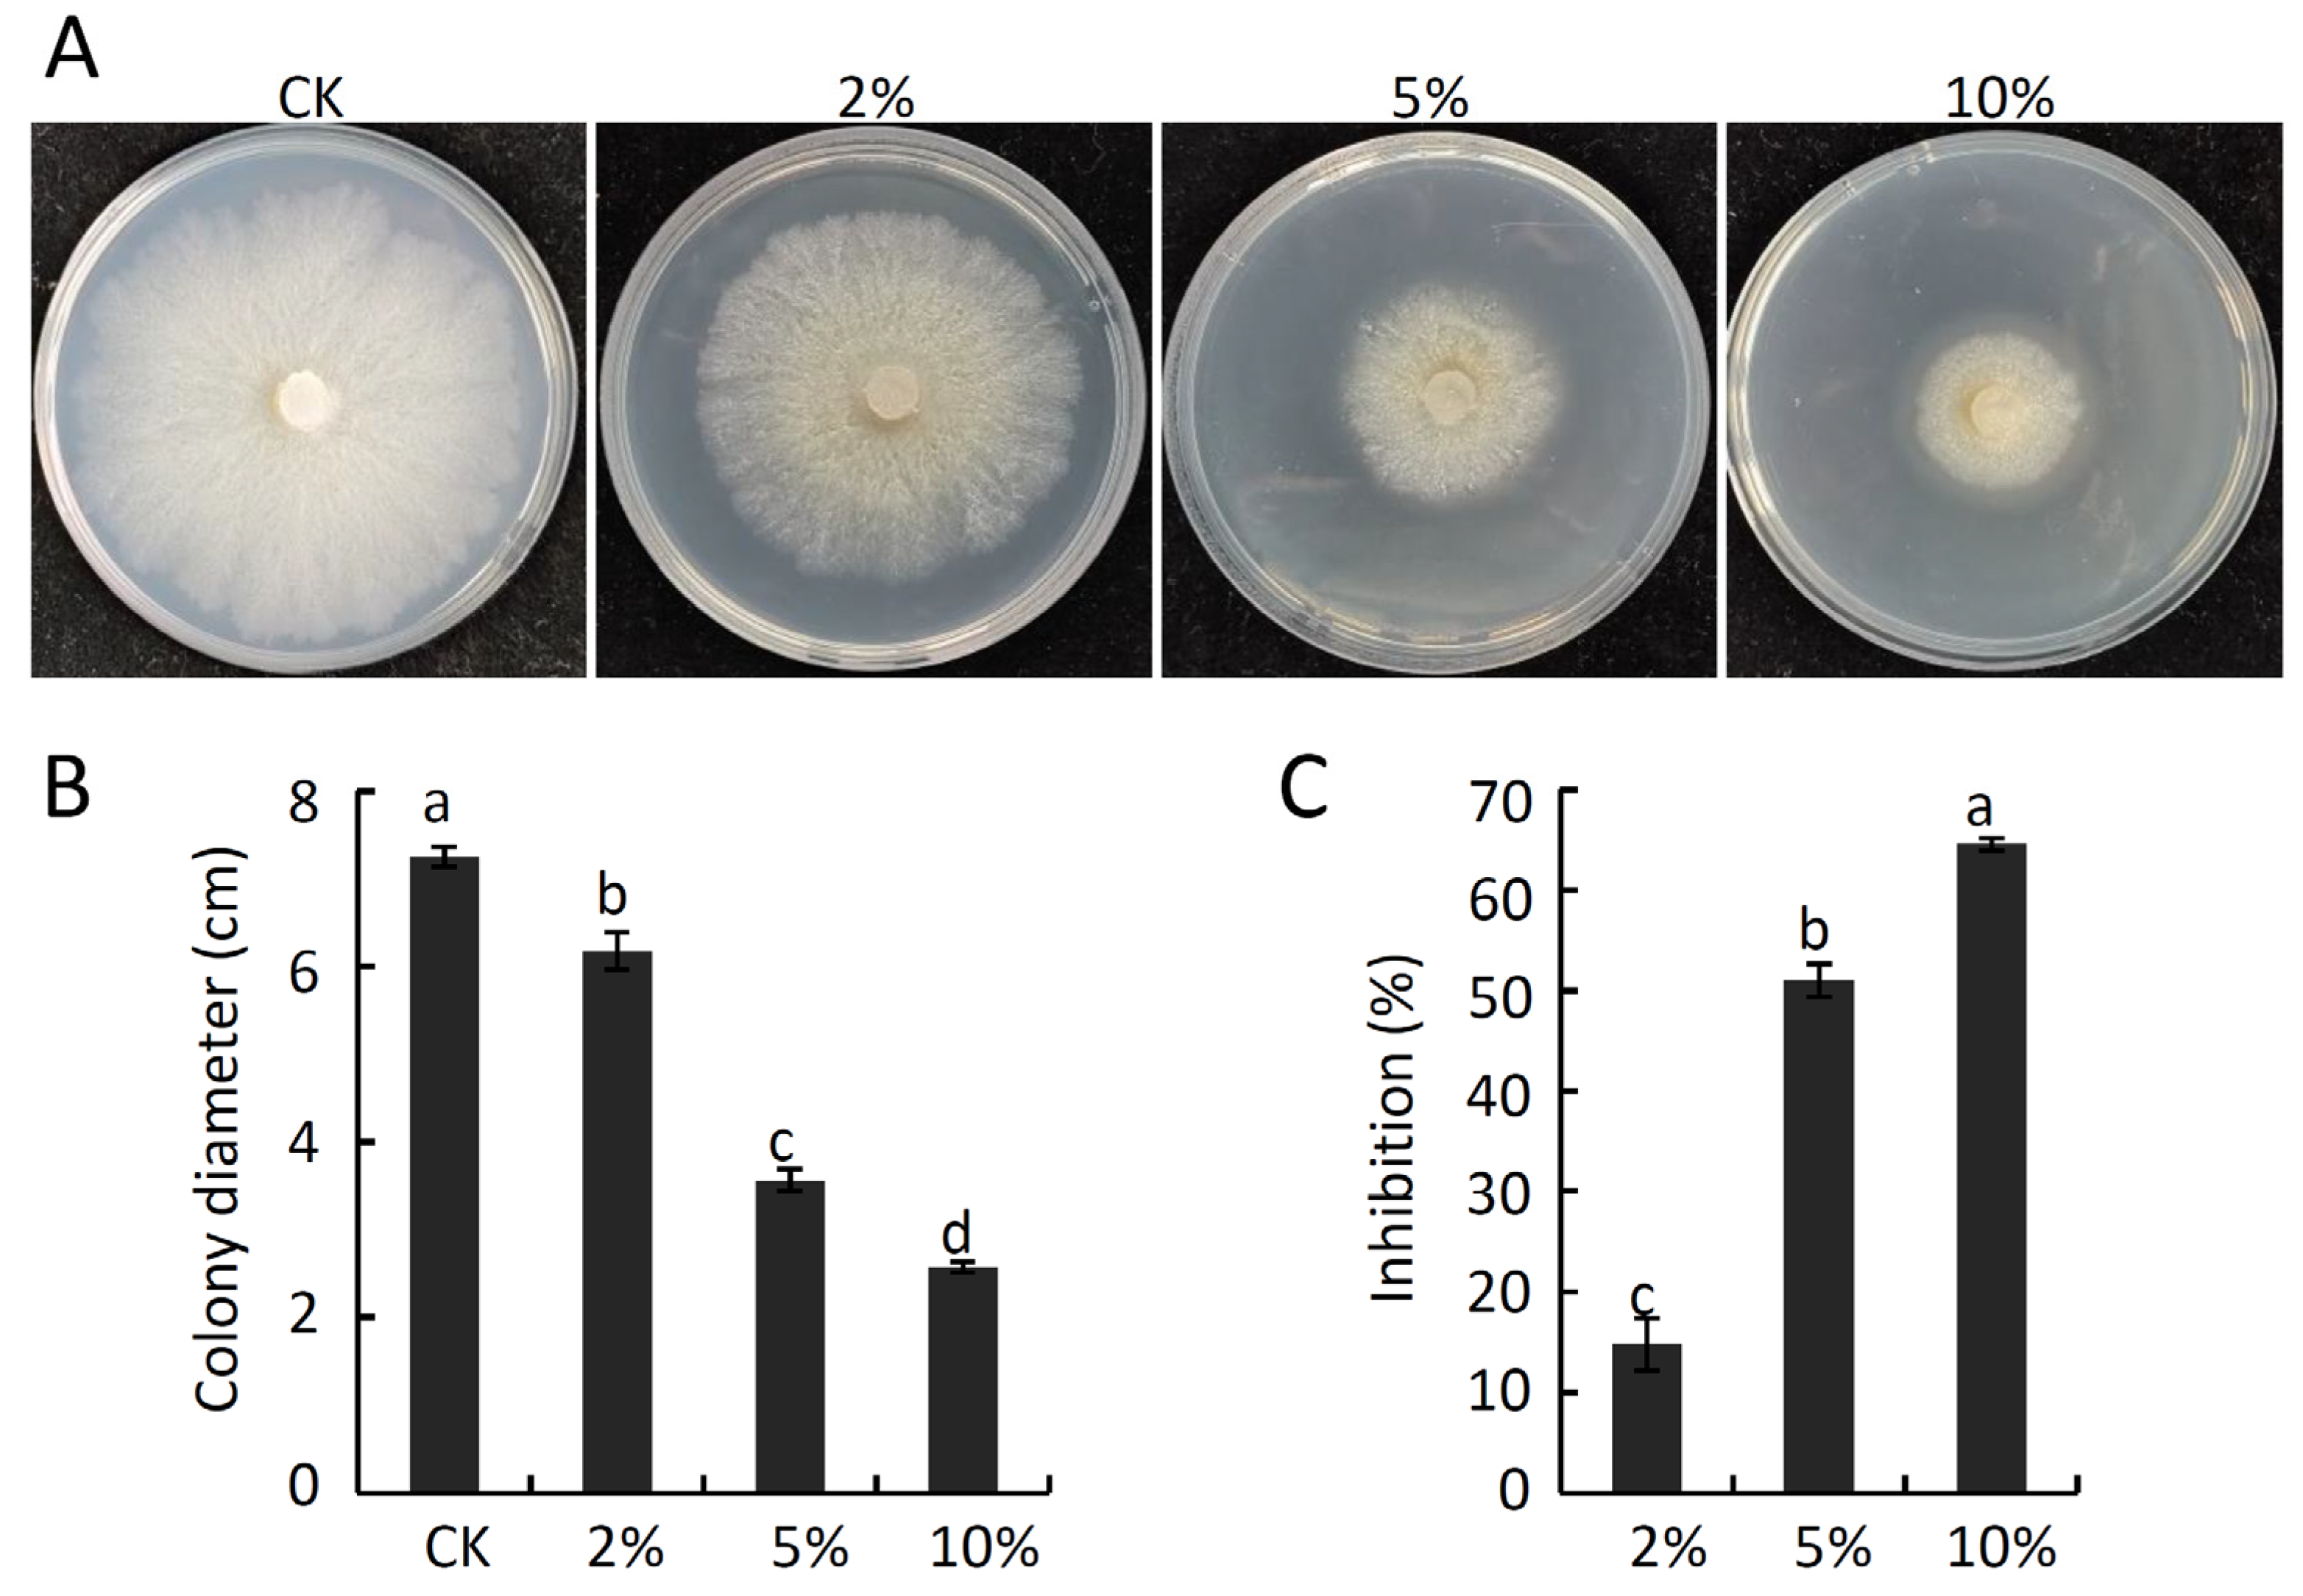
Ijms 24 15477 g004

Exploration of the Biocontrol Activity of Bacillus atrophaeus Strain HF1 against Pear Valsa Canker Caused by Valsa pyri
Abstract
:1. Introduction
2. Results
2.1. Screening for Antagonistic Endophytic Bacteria
2.2. Strain HF1 Identification
2.3. Analyses of the Antifungal Activity of B. atrophaeus Strain HF1 against V. pyri-Induced Pear Valsa Canker
2.4. The Impact of B. atrophaeus Strain HF1 Culture Filtrate on V. pyri Mycelial Growth and Membrane Permeability
2.5. Amplification of B. atrophaeus Strain HF1 Genes Associated with Lipopeptide Biosynthesis
2.6. The Impact of B. atrophaeus Strain HF1-Derived VOCs on V. pyri Mycelial Growth and Membrane Permeability
2.7. Identification of VOCs Produced by B. atrophaeus Strain HF1
2.8. In Vitro Analyses of the Antifungal Activity of Pure VOCs against V. pyri
2.9. Analyses of the Antifungal Activity of Pure VOCs against Pear Valsa Canker
3. Discussion
4. Materials and Methods
4.1. Fungal Pathogens
4.2. Endophytic Bacterial Isolation and Co-Culture Assays
4.3. Identification of Strain HF1
4.4. In Vivo Analysis of the Antifungal Activity of B. atrophaeus Strain HF1 against V. pyri
4.5. Analyses of the Antifungal Activity of B. atrophaeus Strain HF1 Culture Filtrate against V. pyri Mycelial Growth
4.6. Lipopeptide Biosynthesis-Related Genes Amplification
4.7. Analyses of the Antifungal Activity B. atrophaeus Strain HF1-Derived VOCs
4.8. Effect of B. atrophaeus Strain HF1 Culture Filtrate or VOCs on V. pyri Hyphae Membrane Permeability
4.9. Identification of B. atrophaeus Strain HF1-Derived VOCs
4.10. Analysis of the Antifungal Activity of Individual VOCs against Mycelial Growth of Pathogenic Fungi
4.11. Evaluation of the Antifungal Activity of Specific VOCs against Pear Valsa Canker
4.12. Statistical Analysis
5. Conclusions
Supplementary Materials
Author Contributions
Funding
Institutional Review Board Statement
Informed Consent Statement
Data Availability Statement
Acknowledgments
Conflicts of Interest
References
- Cao, S.; Wang, W.; Li, G.; Du, M.; Bi, S.; Zhao, M.; Cao, G.; Li, H. Selection of field control agents and comprehensive control effect of pear Valsa canker. J. Fruit 2018, 35, 143–147. (In Chinese) [Google Scholar]
- Kange, A.M.; Xia, A.; Si, J.; Li, B.; Zhang, X.; Ai, G.; He, F.; Dou, D. The fungal-specific transcription factor VpFSTF1 is required for virulence in Valsa pyri. Front. Microbiol. 2020, 10, 2945. [Google Scholar] [CrossRef] [PubMed]
- Wang, X.; Zang, R.; Yin, Z.; Kang, Z.; Huang, L. Delimiting cryptic pathogen species causing apple Valsa canker with multilocus data. Ecol. Evol. 2014, 4, 1369–1380. [Google Scholar] [CrossRef]
- Yin, Z.; Liu, H.; Li, Z.; Ke, X.; Dou, D.; Gao, X.; Song, N.; Dai, Q.; Wu, Y.; Xu, J.-R.; et al. Genome sequence of Valsa canker pathogens uncovers a potential adaptation of colonization of woody bark. New Phytol. 2015, 208, 1202–1216. [Google Scholar] [CrossRef]
- De Silva, N.I.; Brooks, S.; Lumyong, S.; Hyde, K.D. Use of endophytes as biocontrol agents. Fungal Biol. Rev. 2019, 33, 133–148. [Google Scholar] [CrossRef]
- Cheng, C.; Zhao, Y.; Li, H.; He, F.; Cao, S.; Yang, X.; Qian, G.; Liu, F. Control effect of HSAF from Lysobacter enzymogenes OH11 on pear valsa canker. Chin. J. Biol. Control 2017, 33, 114–120. (In Chinese) [Google Scholar]
- Liu, R.; Li, J.; Zhang, F.; Zheng, D.; Chang, Y.; Xu, L.; Huang, L. Biocontrol activity of Bacillus velezensis D4 against apple Valsa canker. Biol. Control 2021, 163, 104760. [Google Scholar] [CrossRef]
- Yuan, H.; Shi, B.; Huang, T.; Zhou, Z.; Wang, L.; Hou, H.; Tu, H. Biological control of pear Valsa canker caused by Valsa pyri using Penicillium citrinum. Horticulturae 2021, 7, 198. [Google Scholar] [CrossRef]
- Yuan, H.; Yuan, M.; Shi, B.; Wang, Z.; Huang, T.; Qin, G.; Hou, H.; Wang, L.; Tu, H. Biocontrol activity and action mechanism of Paenibacillus polymyxa strain Nl4 against pear Valsa canker caused by Valsa pyri. Front. Microbiol. 2022, 13, 950742. [Google Scholar] [CrossRef]
- Alijani, Z.; Amini, J.; Ashengroph, M.; Bahramnejad, B.; Mozafari, A.A. Biocontrol of strawberry anthracnose disease caused by Colletotrichum nymphaeae using Bacillus atrophaeus strain DM6120 with multiple mechanisms. Trop. Plant Pathol. 2022, 47, 245–259. [Google Scholar] [CrossRef]
- Chacon-Lopez, A.; Guardado-Valdivia, L.; Banuelos-Gonzalez, M.; Lopez-Garcia, U.; Montalvo-González, E.; Arvizu-Gomez, J.; Stoll, A.; Aguilera, S. Effect of metabolites produced by Bacillus atrophaeus and Brevibacterium frigoritolerans strains on postharvest biocontrol of Alternaria alternata in tomato (Solanum lycopersicum L.). Biocontrol Sci. 2021, 26, 67–74. [Google Scholar] [CrossRef] [PubMed]
- Chen, L.; Zhang, H.; Zhao, S.; Xiang, B.; Yao, Z. Lipopeptide production by Bacillus atrophaeus strain B44 and its biocontrol efficacy against cotton rhizoctoniosis. Biotechnol. Lett. 2021, 43, 1183–1193. [Google Scholar] [CrossRef] [PubMed]
- Huang, H.; Wu, Z.; Tian, C.; Liang, Y.; You, C.; Chen, L. Identification and characterization of the endophytic bacterium Bacillus atrophaeus XW2, antagonistic towards Colletotrichum gloeosporioides. Ann. Microbiol. 2015, 65, 1361–1371. [Google Scholar] [CrossRef]
- Mu, Y.; Yue, Y.; Gu, G.; Deng, Y.; Jin, H.; Tao, K. Identification and characterization of the Bacillus atrophaeus strain J-1 as biological agent of apple ring rot disease. J. Plant Dis. Protect. 2020, 127, 367–378. [Google Scholar] [CrossRef]
- Xue, J.; Tong, T.; Wang, R.; Qiu, Y.; Gu, Y.; Sun, L.; Xu, H.; Lei, P. Secretion of poly-γ-glutamic acid by Bacillus atrophaeus NX-12 enhanced its root colonization and biocontrol activity. Front. Microbiol. 2022, 13, 972393. [Google Scholar] [CrossRef]
- Sella, S.R.; Vandenberghe, L.P.; Soccol, C.R. Bacillus atrophaeus: Main characteristics and biotechnological applications—A review. Crit. Rev. Biotechnol. 2015, 35, 533–545. [Google Scholar] [CrossRef]
- Zhang, X.; Li, B.; Wang, Y.; Guo, Q.; Lu, X.; Li, S.; Ma, P. Lipopeptides, a novel protein, and volatile compounds contribute to the antifungal activity of the biocontrol agent Bacillus atrophaeus CAB-1. Appl. Microbiol. Biotechnol. 2013, 97, 9525–9534. [Google Scholar] [CrossRef]
- Rajaofera, M.J.N.; Wang, Y.; Dahar, G.Y.; Jin, P.; Fan, L.; Xu, L.; Liu, W.; Miao, W. Volatile organic compounds of Bacillus atrophaeus HAB-5 inhibit the growth of Colletotrichum gloeosporioides. Pestic. Biochem. Physiol. 2019, 156, 170–176. [Google Scholar] [CrossRef]
- Toral, L.; Rodríguez, M.; Martínez-Checa, F.; Montaño, A.; Cortés-Delgado, A.; Smolinska, A.; Llamas, I.; Sampedro, I. Identification of volatile organic compounds in extremophilic bacteria and their effective use in biocontrol of postharvest fungal phytopathogens. Front. Microbiol. 2021, 12, 773092. [Google Scholar] [CrossRef]
- Zhong, T.; Wang, Z.; Zhang, M.; Wei, X.; Kan, J.; Zalán, Z.; Wang, K.; Du, M. Volatile organic compounds produced by Pseudomonas fluorescens ZX as potential biological fumigants against gray mold on postharvest grapes. Biol. Control. 2021, 163, 104754. [Google Scholar] [CrossRef]
- Zhao, H.; Shao, D.; Jiang, C.; Shi, J.; Li, Q.; Huang, Q.; Rajoka, M.S.R.; Yang, H.; Jin, M. Biological activity of lipopeptides from Bacillus. Appl. Microbiol. Biotechnol. 2017, 101, 5951–5960. [Google Scholar] [CrossRef] [PubMed]
- Stein, T. Bacillus subtilis antibiotics: Structures, syntheses and specific functions. Mol. Microbiol. 2005, 56, 845–857. [Google Scholar] [CrossRef] [PubMed]
- Abdallah, R.B.; Mejdoub-Trabelsi, B.; Nefzi, A.; Jabnoun-Khiareddine, H.; Daami-Remadi, M. Isolation of endophytic bacteria from Withania somnifera and assessment of their ability to suppress Fusarium wilt disease in tomato and to promote plant growth. J. Plant Pathol. Microbiol. 2016, 7, 2–11. [Google Scholar] [CrossRef]
- Wang, F.; Xiao, J.; Zhang, Y.; Li, R.; Liu, L.; Deng, J. Biocontrol ability and action mechanism of Bacillus halotolerans against Botrytis cinerea causing grey mould in postharvest strawberry fruit. Postharvest Biol. Technol. 2021, 174, 111456. [Google Scholar] [CrossRef]
- Weisskopf, L.; Schulz, S.; Garbeva, P. Microbial volatile organic compounds in intra-kingdom and inter-kingdom interactions. Nat. Rev. Microbiol. 2021, 19, 391–404. [Google Scholar] [CrossRef]
- Liu, A.; Zhang, P.; Bai, B.; Bai, F.; Jin, T.; Ren, J. Volatile organic compounds of endophytic Burkholderia pyrrocinia strain JK-SH007 promote disease resistance in poplar. Plant Dis. 2020, 104, 1610–1620. [Google Scholar] [CrossRef]
- Abbaoui, B.; Lucas, C.R.; Riedl, K.M.; Clinton, S.K.; Mortazavi, A. Cruciferous vegetables, isothiocyanates, and bladder cancer prevention. Mol. Nutr. Food Res. 2018, 62, 1800079. [Google Scholar] [CrossRef]
- Recio, R.; Vengut-Climent, E.; Borrego, L.; Khiar, N.; Fernández, I. Biologically active isothiocyanates: Protecting plants and healing humans. Stud. Nat. Prod. Chem. 2017, 53, 167–242. [Google Scholar]
- Lukić, I.; Išić, N.; Ban, D.; Salopek Sondi, B.; Goreta Ban, S. Comprehensive volatilome signature of various Brassicaceae species. Plants 2023, 12, 177. [Google Scholar] [CrossRef]
- Caccalano, M.; Dilarri, G.; Zamuner, C.; Domingues, D.; Ferreira, H. Hexanoic acid: A new potential substitute for copper-based agrochemicals against citrus canker. J. Appl. Microbiol. 2021, 131, 2488–2499. [Google Scholar] [CrossRef]
- Leyva, M.; Vicedo, B.; Finiti, I.; Flors, V.; Del Amo, G.; Real, M.; García-Agustín, P.; González-Bosch, C. Preventive and post-infection control of Botrytis cinerea in tomato plants by hexanoic acid. Plant Pathol. 2008, 57, 1038–1046. [Google Scholar] [CrossRef]
- Rabiei, Z.; Hosseini, S.; Dehestani, A.; Pirdashti, H.; Beiki, F. Exogenous hexanoic acid induced primary defense responses in tomato (Solanum lycopersicum L.) plants infected with Alternaria solani. Sci. Hortic. 2022, 295, 110841. [Google Scholar]
- Yuan, H.; Hou, H.; Zhou, Z.; Tu, H.; Wang, L. Rapid detection of the E198A mutation of carbendazim-resistant isolates in Colletotrichum gloeosporioides by loop-mediated isothermal amplification. Hortic. Plant J. 2022, 8, 289–296. [Google Scholar] [CrossRef]
- Yuan, H.; Yuan, M.; Shi, B.; Wang, Z.; Huang, T.; Zhu, J.; Hou, H.; Wang, L.; Tu, H. Biocontrol activity of Bacillus halotolerans strain Pl7 against Botryosphaeria dothidea causing apple postharvest decay and potential mechanisms. Front. Microbiol. 2023, 13, 1058167. [Google Scholar] [CrossRef] [PubMed]
- Holt, J.G.; Krieg, N.R.; Sneath, P.H.; Staley, J.T.; Williams, S.T. Bergey’s Manual of Determinative Bacteriology, 9th ed.; William & Wilkins: Baltimor, MD, USA, 1994. [Google Scholar]
- Rooney, A.P.; Price, N.P.; Ehrhardt, C.; Swezey, J.L.; Bannan, J.D. Phylogeny and molecular taxonomy of the Bacillus subtilis species complex and description of Bacillus subtilis sub sp. inaquosorum subsp. nov . Int. J. Syst. Evol. Microbiol. 2009, 59, 2429–2436. [Google Scholar] [CrossRef] [PubMed]
- Gao, Y.; Ren, H.; He, S.; Duan, S.; Xing, S.; Li, X.; Huang, Q. Antifungal activity of the volatile organic compounds produced by Ceratocystis fimbriata strains WSJK-1 and Mby. Front. Microbiol. 2022, 13, 1034939. [Google Scholar] [CrossRef]
- Yuan, J.; Raza, W.; Shen, Q.; Huang, Q. Antifungal activity of Bacillus amyloliquefaciens NJN-6 volatile compounds against Fusarium oxysporum f. sp. cubense. Appl. Environ. Microbiol. 2012, 78, 5942–5944. [Google Scholar] [CrossRef]

| Family | Compound | CAS | Molecular Formula | RT (min) | Area (%) |
|---|---|---|---|---|---|
| Alcohols | Methanethiol | 74-93-1 | CH4S | 1.87 | 7.69 |
| 2-pentanol, 3-methyl- | 565-60-6 | C6H14O | 11.87 | 8.49 | |
| (±)-5-methyl-2-hexanol | 111768-09-3 | C7H16O | 14.32 | 16.56 | |
| 2-heptanol, 6-methyl- | 4730-22-7 | C8H18O | 17.01 | 16.67 | |
| 2-heptanol, 5-methyl- | 54630-50-1 | C8H18O | 17.39 | 14.24 | |
| 1-hexanol, 4-methyl- | 818-49-5 | C7H16O | 19.15 | 5.50 | |
| 2-furanmethanol | 98-00-0 | C5H6O2 | 24.10 | 11.15 | |
| Octaethylene glycol | 5117-19-1 | C16H34O9 | 40.10 | 4.03 | |
| Esters | Methyl thiolacetate | 1534-08-3 | C3H6OS | 6.62 | 19.37 |
| Butanoic acid, 2-methyl-, ethyl ester | 7452-79-1 | C7H14O2 | 6.89 | 9.99 | |
| Butanoic acid, 3-methyl-, ethyl ester | 108-64-5 | C7H14O2 | 7.38 | 26.80 | |
| S-methyl 3-methylbutanethioate | 23747-45-7 | C6H12OS | 11.84 | 8.49 | |
| Iberverin | 505-79-3 | C5H9NS2 | 26.35 | 3.84 | |
| Methyl methoxyacetate | 6290-49-9 | C4H8O3 | 29.88 | 3.75 | |
| Ketones | Bis(4-fluorophenyl)methanone | 345-92-6 | C13H8F2O | 2.04 | 7.21 |
| 3-methyl-2-butanone | 563-80-4 | C5H10O | 3.72 | 33.41 | |
| Methyl Isobutyl Ketone | 108-10-1 | C6H12O | 5.46 | 6.64 | |
| 4′-methylvalerophenone | 1671-77-8 | C12H16O | 13.48 | 1.28 | |
| Hydroxyacetone | 116-09-6 | C3H6O2 | 14.68 | 3.95 | |
| Alkanes | Octane, 3-ethyl-2,7-dimethyl- | 62183-55-5 | C12H26 | 14.56 | 3.62 |
| Decane, 6-ethyl-2-methyl- | 62108-21-8 | C13H28 | 20.23 | 12.64 | |
| Octane, 2,4,6-trimethyl- | 62016-37-9 | C11H24 | 25.03 | 7.01 | |
| Ethers | 1-ethoxy-2-propanol | 1569-02-4 | C5H12O2 | 13.09 | 95.76 |
| Tri(propylene glycol) methyl ether | 25498-49-1 | C10H22O4 | 41.66 | 5.69 | |
| Acids | Guanidinopropionic acid | 353-09-3 | C4H9N3O2 | 4.02 | 39.04 |
| Hexanoic acid | 142-62-1 | C6H12O2 | 8.62 | 5.15 | |
| Aldehydes | 2-methylvaleraldehyde | 123-15-9 | C6H12O | 12.33 | 25.42 |
Disclaimer/Publisher’s Note: The statements, opinions and data contained in all publications are solely those of the individual author(s) and contributor(s) and not of MDPI and/or the editor(s). MDPI and/or the editor(s) disclaim responsibility for any injury to people or property resulting from any ideas, methods, instructions or products referred to in the content. |
© 2023 by the authors. Licensee MDPI, Basel, Switzerland. This article is an open access article distributed under the terms and conditions of the Creative Commons Attribution (CC BY) license (https://creativecommons.org/licenses/by/4.0/).
Share and Cite
Yuan, H.; Shi, B.; Wang, Z.; Qin, G.; Hou, H.; Tu, H.; Wang, L. Exploration of the Biocontrol Activity of Bacillus atrophaeus Strain HF1 against Pear Valsa Canker Caused by Valsa pyri. Int. J. Mol. Sci. 2023, 24, 15477. https://doi.org/10.3390/ijms242015477
Yuan H, Shi B, Wang Z, Qin G, Hou H, Tu H, Wang L. Exploration of the Biocontrol Activity of Bacillus atrophaeus Strain HF1 against Pear Valsa Canker Caused by Valsa pyri. International Journal of Molecular Sciences. 2023; 24(20):15477. https://doi.org/10.3390/ijms242015477
Chicago/Turabian StyleYuan, Hongbo, Bingke Shi, Zhuoni Wang, Genhong Qin, Hui Hou, Hongtao Tu, and Li Wang. 2023. "Exploration of the Biocontrol Activity of Bacillus atrophaeus Strain HF1 against Pear Valsa Canker Caused by Valsa pyri" International Journal of Molecular Sciences 24, no. 20: 15477. https://doi.org/10.3390/ijms242015477
APA StyleYuan, H., Shi, B., Wang, Z., Qin, G., Hou, H., Tu, H., & Wang, L. (2023). Exploration of the Biocontrol Activity of Bacillus atrophaeus Strain HF1 against Pear Valsa Canker Caused by Valsa pyri. International Journal of Molecular Sciences, 24(20), 15477. https://doi.org/10.3390/ijms242015477

